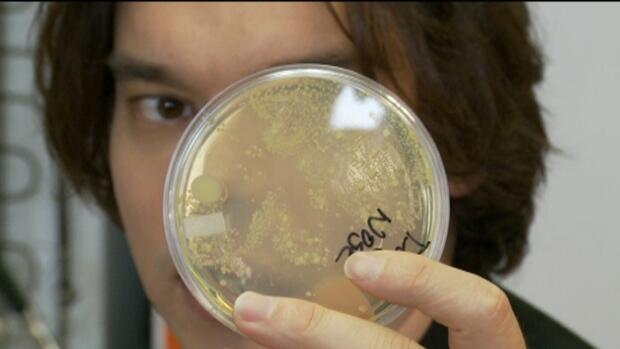
Jomblo? Salahkan Bakteri dalam Tubuh Agan

- Beranda
- The Lounge
Jomblo? Salahkan Bakteri dalam Tubuh Agan
...
TS
vdeanz
Jomblo? Salahkan Bakteri dalam Tubuh Agan



Ada banyak alasan penyebab gagalnya hubungan percintaan seseorang. Misalnya karena pasangan selingkuh, atau visi dan misi tak lagi sejalan. Namun, ada penjelasan ilmiah tentang ketidakcocokan Anda dan pasangan, atau penyebab Anda terus menjomblo.
Spoiler for 1:
Menurut penelitian, bakteri dalam tubuh menjadi salah satu alasan Anda masih lajang. Setiap orang sebenarnya memiliki bakteri dalam tubuhnya. Namun, bakteri yang tidak cocok antara Anda dan si dia-lah yang membuat hubungan percintaan jadi tak sukses. Bisa jadi, bakteri dalam tubuh Anda justru naksir bakteri dalam tubuh pria lain. Bakteri ini sebenarnya memengaruhi kesehatan seseorang agar jadi lebih baik atau buruk. Namun bakteri ini juga akan menentukan keberhasilan hubungan cinta seseorang.
Spoiler for 2:
Bakteri ini juga akan memengaruhi preferensi orang untuk menemukan pasangan lewat aromanya. Analogi sederhananya, seseorang pria yang memiliki aroma menarik untuk Anda belum tentu tercium wangi untuk orang lain. Hal ini disebabkan karena bakteri di dalam tubuh orang lain itu ‘berselisih’ dengan bakteri yang ada di dalam tubuh pria idola Anda. "Bakteri tak hanya bisa mendeteksi pria yang cocok jadi pasangan hanya dari baunya saja. Bau hanyalah respons pertama," kata kata Jason Tetro, ahli mikrobiologi dan penulis buku The Germ Code, dilansir dari Your Tango, Selasa (23/12).
Spoiler for Jason Tetro:
Ketika Anda merasa cocok dengan satu orang, bisa jadi bakteri Anda juga cocok dengan bakteri di dalam tubuhnya. Sebagai contoh, penelitian menunjukkan ciuman akan mentransfer 80 juta bakteri ke kedua pasangan. Dengan demikian, hal ini akan merangsang sistem kekebalan tubuh. Jika bakteri ini sama-sama cocok, maka respons selanjutnya adalah timbulnya perasaan bahagia.
Spoiler for 4:
Sebaliknya, jika bakteri ini tidak selaras, maka sama seperti reaksi alergi, orang tersebut akan merasa tak nyaman, bahkan defensif.
Spoiler for 5:
Lalu bisakah manusia mengubah mikroba di dalam tubuhnya? Jawabannya, bisa. Mikroba atau bakteri ini akan berubah seiring dengan perubahan gaya hidup, geografi dan diet. Cara termudah untuk mengubah ‘kepribadian’ bakteri ini adalah dengan mengonsumsi antibiotik dan probiotik.
Spoiler for sumber:
Spoiler for sumber:

Diubah oleh vdeanz 25-12-2014 09:39
0
1.5K
20
Komentar yang asik ya
Mari bergabung, dapatkan informasi dan teman baru!
The Lounge
1.3MThread•105.8KAnggota
Urutkan
Terlama
Komentar yang asik ya